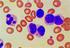
EVALUASI HASIL PEMERIKSAAN POLA HITUNG JENIS SEL DARAH PEKERJA RADIASI

Hitung Diferensial dan Kelainan-Kelainan Sel Darah Sapi Bali
|
|
|
- Glenna Budiaman
- 9 tahun lalu
- Tontonan:
Transkripsi
1 Jurnal Veteriner Desember 203 Vol. 4 No. 4: ISSN : Hitung Diferensial dan Kelainan-Kelainan Sel Darah Sapi Bali (DIFFERENTIAL COUNT AND ABNORNALITIES OF BALI CATTLE BLOOD CELLS) Iwan Harjono Utama, 2 Anak Agung Sagung Kendran, 3 Sri Kayati Widyastuti, Putri Virgania, Sherliyanti Maria Sene, Widarta Dwi Kusuma, Baiq Yunita Arisandi Laboratorium Biokimia Veteriner, 2 Laboratorium Patologi Klinik Veteriner, 3 Lab Penyakit Dalam Hewan Kecil Fakultas Kedokteran Hewan, Universitas Udayana, Jln P. B. Sudirman Denpasar, Telp ; [email protected] ABSTRAK Penelitian mengenai gambaran sediaan ulas darah dan berbagai kelainannya pada sapi bali telah dilakukan pada 24 ekor sapi jantan dan 76 ekor sapi betina. Spesimen darah diambil dari sapi sapi yang dipotong di Rumah Potong Hewan Mambal Kabupaten Badung-Bali dan pembuatan sediaan ulas dilakukan dengan metode yang telah banyak dibahas di berbagai pustaka. Hasil penelitian memperlihatkan bahwa nilai rataan hitung jenis leukosit yang meliputi : limfosit, monosit, neutrofil, eosinofil, basofil dan band sapi bali betina berturut-turut adalah (rataan + simpangan baku) : (47,76 ±2,3)%; (9,84 ± 5,32)%; (39,09 ± 2,55)%; (2,25 ± 2,40)%; (0,33 ±,8)%; (0,2 ±,0)%. Sedangkan pada sapi bali jantan diperoleh hasil (46,48 ± 8,8)%; (9,84 ± 4,35)%; (40,5 ± 8,29)%; (,48 ±,69)%; (0,45 ± 0,84)%; (0,57 ± 0,99)%. Kelainan-kelainan yang dijumpai pada lekosit adalah : eosinopenia, monositosis, neutrofilia, limfopenia, dan limfositosis. Sedangkan kelainan pada eritrosit berupa : anisositosis, poikilositosis (adanya akantosit, dakrosit), dan hipokromasia. Dapat disimpulkan : sapi bali yang diamati mengalami kelainan pada sel sel darahnya. Kata kunci : sapi bali sediaan ulas darah ABSTRACT Research on blood smear and various disorder in Bali cattle have been conducted at 24 oxen and 76 cows. Blood specimens taken from cattle slaughtered cattle in Slaughterhouse Mambal Badung Regency, Bali and blood smear were performed by a method described elsewhere. Results showed the mean of differential count of lymphocytes, monocytes, neutrophils, eosinophils, basophils and bands in female Bali cattle bands respectively (average + standard deviation): (47.76 ± 2.3)%, (9.84 ± 5, 32)%, (39.09 ± 2.55)%, (2.25 ± 2.40)%, (0.33 ±.8)%, (0.2 ±.0)%. In bali cattle males, those results were : (46.48 ± 8.8)%, (9.84 ± 4.35)%, (40.5 ± 8.29)%, (.48 ±.69)%; (0.45 ± 0.84)%, (0.57 ± 0.99)%. Abnormalities that were found are: eosinophenia, monocytosis, Neutrophilia, lymphopenia and lymphocytosis, anisocytosis, poikilocytosis (the presence of akhantocytes, dacrocyt), and hypochromasia. In summary Bali cattle are observed to have abnormalities in the blood cells. Key words : bali cattle blood smear PENDAHULUAN Sapi bali merupakan hewan ternak asli Indonesia yang keberadaannya sangat penting bagi masyarakat di Bali karena memiliki keunggulan sebagai ternak kerja dan ternak potong (Oka, 2003). Beberapa kajian mengenai kesehatan sapi bali telah banyak dipublikasi, khususnya mengenai penyakit jembrana (Wilcox et al., 997) dan penyakit Bali Ziekte (Ressang, 984). Hartaningsih et al., (983) telah mengamati gambaran ulas darah tepi sapi bali khususnya mengenai hitung jenis leukosit dengan hasil sebagai berikut: neutrofil 2-54%; limfosit 3-76%; monosit 0-5%; dan eosinofil 2-30%, tetapi mereka tidak merinci kelainan apa saja yang dijumpai dari ulas darah yang diamatinya. 462
2 Utama et al Jurnal Veteriner Berbagai alasan yang menjadikan pemeriksaan ulas darah ini penting dilakukan (Bain, 2005). Meskipun sudah ada instrumen elektronik yang bekerja berdasarkan geometri sel darah (Angulo dan Frandlin, 2003; Weiss, 2002), pemeriksaan ulas darah yang terbaik masih mengandalkan manusia (Davis dan Bigelow, 999), hal tersebut disebabkan instrumen elektronik umumnya belum terprogram untuk mengamati berbagai kelainan sitopatologis sel darah (Hillman, 200) dan manusia lebih mampu mengamati berbagai kelainan tersebut dengan lebih cermat (Houwen, 200; Beaudoin, et al., 2002). Atas dasar itulah, penelitian ini dilakukan dengan tujuan mengetahui nilai rataan persentase berbagai jenis leukosit sapi bali serta mengamati berbagai kelainan yang ada (berdasarkan morfologi sel dan ukurannya) pada sediaan gambaran ulas darahnya. METODE PENELITIAN Penelitian ini dilakukan dengan menggunakan spesimen darah ulas dari 200 ekor sapi bali (24 betina dan 76 jantan) yang dipotong di Rumah Pemotongan Hewan Mambal, Abian Semal, Kabupaten Badung, Bali. Pembuatan sediaan ulas dan pewarnaan dilakukan dengan cara yang telah banyak dipublikasikan di berbagai referensi (Laedinger, 2002; Swalley, 98). Pengambilan spesimen darah dilakukan saat hewan dipotong dan dari darah yang keluar diambil setetes darah yang kemudian ditaruh di ujung kaca objek dan segera dibuat sediaan ulas. Setelah dikeringkan dengan cara mengangin-anginkannya, sediaan ulas kemudian difiksasi menggunakan larutan methanol absolut selama lima menit (Merck, USA) diwarnai dengan metode pewarnaan Giemsa (Houwen, 2000). Setelah sediaan kering kemudian disimpan dan diamati di laboratorium menggunakan mikroskop (Olympus CX-5, Japan) dengan pembesaran 000 kali dengan metode cross sectional (Weiss dan Wardrop, 200). Objek yang diamati meliputi jenis lekosit dan eritrosit serta trombosit. Selain itu pula dilakukan perhitungan jenis lekosit dan pengamatan terhadap kelainan morfologi lekosit. Kelainan eritrosit dilihat berdasarkan warna, bentuk, dan ukurannya. Selain itu juga diamati keberadaan eritrosit muda (retukulosit) pada sediaan ulas darah tersebut untuk menilai regeneratif atau tidaknya anemia. Warna eritrosit bisa memprediksi keberadaan anemia hipokromik. Pengamatan trombosit dilakukan terhadap distribusi trombosit dan nilai rataan dari 0 lapang pandang, dan komposisi trombosit muda dan dewasa. Evaluasi sediaan dilakukan berdasarkan acuan dari Milles, (998); Houwen, (200); Hookey, et al., (200); Stokol, (2006). Analisis data dilakukan secara diskriptif dengan cara tabulasi dan membuat histogram (Nasoetion dan Barizi, 980). HASIL DAN PEMBAHASAN Hasil dari penelitian ini (Gambar ) memperlihatkan bahwa gambaran differensial leukosit sapi bali mirip dengan apa yang didapat oleh Hartaningsih et al., (983). Ditemukan juga banyak kelainan seperti tertera pada Tabel. Jenis kelainan yang ditemukan terkait dengan fungsi leukosit ialah eosinopenia dengan persentase tertinggi kemudian diikuti dengan monositosis, neutrofilia, dan limfopenia. Teramati juga keberadaan pergeseran ke kiri (shift to the left) dari sel netrofil yang ada. Mengenai jumlah trombosit masih sesuai dengan nilai normal yang didapat dari Stokol (996). Pada Tabel disajikanbahwa hipokromasia dan anisositosis eritrosit merupakan kasus dominan dijumpai pada sapi bali yang diamati. Adanya fenomena tersebut terkait dengan proses deposisi zat besi yang kurang baik dan eritropoesis yang abnormal di sumsum tulang Gambar 2. Respons leukogenesis / shift to the left yang ditunjukkan oleh adanya granulosit muda (tanda panah). 463
3 Jurnal Veteriner Desember 203 Vol. 4 No. 4: (Fritsch dan Nelson, 990). Walaupun demikian adanya retikulosit yang teramati pada sediaan ulas darah sapi sapi yang mengalami anemia menunjukan adanya proses regeneratif dari keadaan anemia tersebut (Lording, 998; Meyer dan Harvey, 2004). Berbagai kelainan yang terkait dengan eritrosit seperti : anisositosis, hipokromasia, dan poikilositosis juga teramati. Tampaknya kelainan-kelainan ini disebabkan gangguan eritropoesis pada sumsum Tulang (Purwoko et al., 2000) yang bisa disebabkan oleh defisiensi nutrisi seperti vitamin B2, atau cobalt. Kelainan tersebut mungkin juga disebabkan oleh penyakit yang menyerang sumsum tulang, sedangkan akantosit mungkin disebabkan oleh adanya penyakit anemia hemolitik akibat reaksi autoimun. Dakrosit disebabkan adanya gangguan fungsi limpa dan gangguan mieloproliferatif (Cowell, 2004). Meskipun data ini belum ada, tetapi penting untuk menjadi target pengamatan di penelitian mendatang. Dari gambaran leukosit bisa teramati adanya monositosis, limfositosis, neutrofilia, limfopenia, dan eosinopenia. Eosinopenia merupakan temuan yang cukup dominan pada sapi bali. Hal tersebut mungkin terkait dengan stres atau akibat penekanan granulopoeisis, sedangkan peningkatan monosit atau monositosis disebabkan oleh peradangan yang kronis atau pembentukan granuloma (Kerr, 2002, Mills, 998). Eosinofilia juga mungkin Tabel. Hasil pengamatan Abnormalitas leukosit, Eritrosit dan trombosit dari 200 ekor Sapi Bali. Kelainan Leukosit Jantan Betina Monositosis (%) 8,0 3,0 Limfositosis (%) 2,0 - Limfopenia (%) 3,3,7 Neutrofilia (%) 3,9 2, Eosinofenia (%) 2,8 3,2 Shift to left /pergeseran 5,9, ke kiri (%) Kelainan eritrosit Jantan Betina Hipokromasia (%) 2,3 8,5 Anisositosis (%) 22, 2,7 Acantosit (%) 7,0 3,0 Poikilosit (%) 2,3 2,4 Dacrosit (%),0 - Anemia regeneratif (%) 2,7 3,5 Trombosit (rata sel per lapang pandang lensa objektif 00x) Rasio jumlah trombosit 0,3 0,45 muda terhadap dewasa (rataan sel per lapang pandang lensa objektif 00x) Keterangan Tabel : nilai % menunjukkan persentase contoh darah sapi sapi yang dijumpai mengalami kelainan dari 200 spesimen darah yang diperiksa Gambar. Distribusi leukosit pada sediaan ulas darah dari 200 ekor sapi bali, angka menunjukkan nilai persentase (limf : limfosit, mono : monosit, Neu : netrofil, eos : eosinofil, Bas : basofil). 464
4 Utama et al Jurnal Veteriner terkait dengan peradangan internal seperti sinovitis (Silverstein et al., 2000). Salah satu penyebab eosinofilia ialah adanya kelainan pada organ hati sapi-sapi tersebut yang menunjukkan banyaknya kelainan kronis seperti: penebalan dinding saluran empedu, perdarahan, dan pembentukan jaringan ikat atau fibrosis. Prosesproses tersebut merupakan proses kronik (Utama, 200). SIMPULAN Dapat disimpulkan bahwa sel sel darah sapi bali yang teramati menhgalami kelainan seperti : eosinopenia, monositosis, neutrofilia, limfopenia, dan limfositosis, sedangkan kelainan pada eritrosit yang ditemukan adalah: anisositosis, poikilositosis (adanya acantosit, dacrosit), dan hipokromasia. SARAN Penelitian ini sebaiknya dilanjutkan dengan melakukan pengamatan terhadap berbagai organ yang terkait dengan adanya kelainan yang dijumpai pada pemeriksaan ulas darah seperti pemeriksaan sumsum tulang. Ucapan terima kasih ditujukan kepada kepala Rumah Potong Hewan ammambal Badung atas fasilitas yang disediakan dan juga kepada Laboratorium Biokimia Veteriner, Laboratorium Patologi Klinik Veteriner dan Laboratorium Histologi Veteriner Fakultas Kedokteran Hewan Universitas Udayana. DAFTAR PUSTAKA Anguilo J, dan Flandrin G Automatd detection of working area of peripheral blood smears using mathematical morphology. Anal Cell Pathol 25 : Bain J B Current concepts : diagnosis from the blood smear. New Engl J Med 353 : Beaudoin S, Lanevschi A, Dunn M, Desnoyers M Peripheral blood smear from a dog. Vet Clin Pathol 3 : Cowell RL Veterinary Clinical pathology Secrets. St. Louis Misoury, USA. Elsevier, Mosby Davis B H, Bigelow N C Performance evaluation of a hematology blood counter with five-part leucocyte differential capability. Am Clin Laboratory Nov- Dec : 8-9. Fritsch G, Nelson R T Bovine Erythroid (CFU-E, BFU-E) and Granulocyte- Macrophage Colony Formation in Culture. Exp Hematol 8 : Hartaningsih N, Sudana G, Malole MBM The blood picture of Bali cattle in Bali. Hemera Zoa Indonesian Journal of Animal Science 7(2) Hillman R Bloodsmear interpretation : How about the ByWhom. Lab Hematol 7 : 74. Hookey L, Dexter D, Lee DH The use and interpretation of quantitative terminology in reporting of red blood cell morphology. Lab Hematol 7 : Houwen B Blood film preparation and staining procedures. Lab Hematol 6 : -7. Houwen B The differential cell count. Lab Hematol 7 : Kerr MG Veterinary Laboratory Medicine : Clinical Biochemistry and Haematology. Oxford. Blackwell Science. Leidinger E Basics for the evaluation of blood smears ini dogs and cats. Waltham Focus 2() : ( Lording P Interpretation of laboratory profiles. Aust Vet Pract 8 : 2-3. Mills JN Interpreting blood smears (or what blood smears are trying to tell you!). Aust Vet J 76 (9) : ). Meyer DJ, Harvey JH Veterinary laboratory medicine : Interpretation and diagnosis. 3rd Ed. Saunders. Nasoetion AH, Barizi Metoda Statistika. Jakarta. Penerbit Gramedia. Oka L Performance of Bali Cattle Heifers and Calves prior to Weaning in a Feedlot System. Strategies to Improve Bali Cattle in Eastern Indonesia, edited by K. Entwistle and D.R. Lindsay. ACIAR Proceedings No 0 : 4-6. Ressang AA Patologi Khusus Veteriner. Denpasar. Bali. Edisi Kedua. Silverstein DC, Almy FS, Zinkl JG, Christopher MM Idiopathic localized eosinophilic synovitis in a cat. Vet Clin Pathol 29 : Stokol T Trombocytes ahdc.vet.cornell.edu/clinpath/modules/ heme/ plts.htm 465
5 Jurnal Veteriner Desember 203 Vol. 4 No. 4: Swalley J. 98. Improving blood smear and staining techniques. Vet Med and Small Anim Clin 76 : Utama IH, Rumlaklak YY, Karmi DAD, Kendran AASWidyastuti SK, Berata IK, Setiasih LK Keterkaitan antara turbiditas serum dan laju endap darah dengan kerusakan hati pada sapi bali. Jurnal Veteriner : Purwoko S, Utama IH, Kendran AAS Gambaran sediaan ulas sumsum tulang sapi bali. Denpasar. Fakultas Kedokteran Hewan, Universitas Udayana. Weiss DJ Application of flow cytometric techneques to veterinary clinical hematology. Vet Clin Pathol 3 : Weiss DJ, Wardrop KJ Schalm s veterinary hematology 6 th Ed. Singapore. Blackwell Publishing Ltd. Wilcox GE, Suharsono, Dharma DMN, Copland JW Jembrana Disease and The Bovine Lentiviruses. (ACIAR Proceedings No.75) Proceedings of a workshop 0-3 June 996, Bali Indonesia Direktorat Jendral Peternakan and The Bali Cattle Dissease Investigation Unit. 466
ABSTRAK. Kata kunci : kambing kacang, eritrosit, Denpasar Barat
 ABSTRAK Telah dilakukan penelitian pada 40 ekor kambing kacang betina. Penelitian ini bertujuan untuk mengetahui gambaran sitologi sel darah abnormal pada kambing kacang yang berada di Rumah Potong Kambing
ABSTRAK Telah dilakukan penelitian pada 40 ekor kambing kacang betina. Penelitian ini bertujuan untuk mengetahui gambaran sitologi sel darah abnormal pada kambing kacang yang berada di Rumah Potong Kambing
Waktu Beku Darah Sapi Bali
 Waktu Beku Darah Sapi Bali BLOOD CLOOTING TIME IN BALI CATTLE Azmil Umur 1, Sri Kayati Widyastuti 2, Iwan Harjono Utama 3 1 Mahasiswa Program Pendidikan Dokter Hewan 2 Laboratorium Ilmu Penyakit Dalam
Waktu Beku Darah Sapi Bali BLOOD CLOOTING TIME IN BALI CATTLE Azmil Umur 1, Sri Kayati Widyastuti 2, Iwan Harjono Utama 3 1 Mahasiswa Program Pendidikan Dokter Hewan 2 Laboratorium Ilmu Penyakit Dalam
Gambaran Sitologi Sediaan Ulas Darah Kambing Kacang yang didapat dari Rumah Potong Kambing Tradisional di Denpasar Barat
 Gambaran Sitologi Sediaan Ulas Darah Kambing Kacang yang didapat dari Rumah Potong Kambing Tradisional di Denpasar Barat (CYTOLOGY FIGURES OF DOMESTIC GOAT S BLOOD SMEAR FROM TRADITIONAL ABATTOIR IN WEST
Gambaran Sitologi Sediaan Ulas Darah Kambing Kacang yang didapat dari Rumah Potong Kambing Tradisional di Denpasar Barat (CYTOLOGY FIGURES OF DOMESTIC GOAT S BLOOD SMEAR FROM TRADITIONAL ABATTOIR IN WEST
PROFIL SEL DARAH PUTIH (Leucocyte) SAPI BALI DI KECAMATAN BANGKINANG SEBERANG KABUPATEN KAMPAR
 SKRIPSI PROFIL SEL DARAH PUTIH (Leucocyte) SAPI BALI DI KECAMATAN BANGKINANG SEBERANG KABUPATEN KAMPAR Oleh : Rosnaini 10981008304 JURUSAN ILMU PETERNAKAN FAKULTAS PERTANIAN DAN PETERNAKAN UNIVERSITAS
SKRIPSI PROFIL SEL DARAH PUTIH (Leucocyte) SAPI BALI DI KECAMATAN BANGKINANG SEBERANG KABUPATEN KAMPAR Oleh : Rosnaini 10981008304 JURUSAN ILMU PETERNAKAN FAKULTAS PERTANIAN DAN PETERNAKAN UNIVERSITAS
Waktu Retraksi Bekuan Darah pada Sapi Bali
 Waktu Retraksi Bekuan Darah pada Sapi Bali BLOOD CLOT RETRACTION TIME IN BALI CATTLE Juli Yanti 1, Iwan Harjono Utama 2, Sri Kayati Widyastuti 3 1 Mahasiswa Program Pendidikan Dokter Hewan 2 Laboratorium
Waktu Retraksi Bekuan Darah pada Sapi Bali BLOOD CLOT RETRACTION TIME IN BALI CATTLE Juli Yanti 1, Iwan Harjono Utama 2, Sri Kayati Widyastuti 3 1 Mahasiswa Program Pendidikan Dokter Hewan 2 Laboratorium
!"#!$%&"'$( )) Kata kunci: Differential counting, zona atas dan bawah
 DIFFERENTIAL COUNTING BERDASARKAN ZONA BACA ATAS DAN BAWAH PADA PREPARAT DARAH APUS Budi Santosa FakultasIlmu Keperawatan dan Kesehatan, Universitas Muhammadiyah Semarang Jl. Kedungmundu Raya no.18 Semarang,
DIFFERENTIAL COUNTING BERDASARKAN ZONA BACA ATAS DAN BAWAH PADA PREPARAT DARAH APUS Budi Santosa FakultasIlmu Keperawatan dan Kesehatan, Universitas Muhammadiyah Semarang Jl. Kedungmundu Raya no.18 Semarang,
HASIL DAN PEMBAHASAN
 HASIL DAN PEMBAHASAN Hematologi Hasil pemeriksaan hematologi disajikan dalam bentuk rataan±simpangan baku (Tabel 1). Hasil pemeriksaan hematologi individual (Tabel 5) dapat dilihat pada lampiran dan dibandingkan
HASIL DAN PEMBAHASAN Hematologi Hasil pemeriksaan hematologi disajikan dalam bentuk rataan±simpangan baku (Tabel 1). Hasil pemeriksaan hematologi individual (Tabel 5) dapat dilihat pada lampiran dan dibandingkan
BAB I PENDAHULUAN A. Latar Belakang Penelitian. pemeriksaan kultur darah menyebabkan klinisi lambat untuk memulai terapi
 BAB I PENDAHULUAN A. Latar Belakang Penelitian Deteksi dini bakteremia memfasilitasi inisiasi terapi antimikroba, mengurangi morbiditas dan mortalitas, dan mengurangi biaya kesehatan hal ini menjadi tujuan
BAB I PENDAHULUAN A. Latar Belakang Penelitian Deteksi dini bakteremia memfasilitasi inisiasi terapi antimikroba, mengurangi morbiditas dan mortalitas, dan mengurangi biaya kesehatan hal ini menjadi tujuan
HASIL DAN PEMBAHASAN
 HASIL DAN PEMBAHASAN Berdasarkan penelitian yang dilakukan pada kerbau lumpur betina, diperoleh jumlah rataan dan simpangan baku dari total leukosit, masing-masing jenis leukosit, serta rasio neutrofil/limfosit
HASIL DAN PEMBAHASAN Berdasarkan penelitian yang dilakukan pada kerbau lumpur betina, diperoleh jumlah rataan dan simpangan baku dari total leukosit, masing-masing jenis leukosit, serta rasio neutrofil/limfosit
Diferensial Granulosit Sapi Bali di Dataran Tinggi dan Rendah di Nusa Penida
 Buletin Veteriner Udayana Volume 10 No. 1: 81-86 pissn: 2085-2495; eissn: 2477-2712 Pebruari 2018 Online pada: http://ojs.unud.ac.id/index.php/buletinvet DOI: 10.24843/bulvet.2018.10.1.81 Diferensial Granulosit
Buletin Veteriner Udayana Volume 10 No. 1: 81-86 pissn: 2085-2495; eissn: 2477-2712 Pebruari 2018 Online pada: http://ojs.unud.ac.id/index.php/buletinvet DOI: 10.24843/bulvet.2018.10.1.81 Diferensial Granulosit
I Putu Cahyadi Putra NrM s026
 PENGARUH PEMBERIAN MINERAL TERHADAP DIFERENSIAL LEUKOSIT SAPI BALI PADA EMPAT TIPE LAHAN BERBEDA SKRIPSI Diajukan Untuk Melengkapi Tugas - Tugas dan Memenuhi Persyaratan untuk Mencapai Gelar Sarjana Kedokteran
PENGARUH PEMBERIAN MINERAL TERHADAP DIFERENSIAL LEUKOSIT SAPI BALI PADA EMPAT TIPE LAHAN BERBEDA SKRIPSI Diajukan Untuk Melengkapi Tugas - Tugas dan Memenuhi Persyaratan untuk Mencapai Gelar Sarjana Kedokteran
HASIL DAN PEMBAHASAN
 18 HASIL DAN PEMBAHASAN Jumlah LeukositTotal Leukosit merupakan unit darah yang aktif dari sistem pertahanan tubuh dalam menghadapi serangan agen-agen patogen, zat racun, dan menyingkirkan sel-sel rusak
18 HASIL DAN PEMBAHASAN Jumlah LeukositTotal Leukosit merupakan unit darah yang aktif dari sistem pertahanan tubuh dalam menghadapi serangan agen-agen patogen, zat racun, dan menyingkirkan sel-sel rusak
ABSTRAK. Billy Lesmana, 2009; Pembimbing I : Lisawati Sadeli, dr, M.Kes Pembimbing II : Fanny Rahardja, dr, M.Si
 ABSTRAK Gambaran Leukosit dan Hitung Jenis pada Pasien Rawat Inap Demam Tifoid dengan Gall Culture Positif di RS Immanuel periode Januari 2007 Juni 2008 Billy Lesmana, 2009; Pembimbing I : Lisawati Sadeli,
ABSTRAK Gambaran Leukosit dan Hitung Jenis pada Pasien Rawat Inap Demam Tifoid dengan Gall Culture Positif di RS Immanuel periode Januari 2007 Juni 2008 Billy Lesmana, 2009; Pembimbing I : Lisawati Sadeli,
ABSTRAK KESESUAIAN PERHITUNGAN NILAI RATA-RATA ERITROSIT FLOW CYTOMETER DENGAN GAMBARAN POPULASI ERITROSIT PADA PEMERIKSAAN SEDIAAN APUS DARAH TEPI
 ABSTRAK KESESUAIAN PERHITUNGAN NILAI RATA-RATA ERITROSIT FLOW CYTOMETER DENGAN GAMBARAN POPULASI ERITROSIT PADA PEMERIKSAAN SEDIAAN APUS DARAH TEPI Vivin Maria, 2006, Pembimbing I : Penny Setyawati M,
ABSTRAK KESESUAIAN PERHITUNGAN NILAI RATA-RATA ERITROSIT FLOW CYTOMETER DENGAN GAMBARAN POPULASI ERITROSIT PADA PEMERIKSAAN SEDIAAN APUS DARAH TEPI Vivin Maria, 2006, Pembimbing I : Penny Setyawati M,
BAB I PENDAHULUAN Latar Belakang
 1 BAB I PENDAHULUAN 1.1. Latar Belakang Upaya kesehatan transfusi darah adalah upaya kesehatan berupa penggunaan darah bagi keperluan pengobatan dan pemulihan kesehatan. Sebelum dilakukan transfusi darah
1 BAB I PENDAHULUAN 1.1. Latar Belakang Upaya kesehatan transfusi darah adalah upaya kesehatan berupa penggunaan darah bagi keperluan pengobatan dan pemulihan kesehatan. Sebelum dilakukan transfusi darah
Suplementasi Mineral Pada Pakan Sapi Bali Terhadap Diferensial Leukosit Di Empat Tipe Lahan
 Suplementasi Mineral Pada Pakan Sapi Bali Terhadap Diferensial Leukosit Di Empat Tipe Lahan (MINERAL SUPPLEMENTATION ON BALINESE CATTLE TOWARD LEUCOCYTE DIFFERENTIAL IN FOUR TYPES OF LAND) I Putu Cahyadi
Suplementasi Mineral Pada Pakan Sapi Bali Terhadap Diferensial Leukosit Di Empat Tipe Lahan (MINERAL SUPPLEMENTATION ON BALINESE CATTLE TOWARD LEUCOCYTE DIFFERENTIAL IN FOUR TYPES OF LAND) I Putu Cahyadi
KETERKAITAN ANTARA SIFAT FISIK EMPEDU TERHADAP KELAINAN ORGAN HATI SAPI BALI SKRIPSI. Oleh Eva Candra Ardia NIM
 KETERKAITAN ANTARA SIFAT FISIK EMPEDU TERHADAP KELAINAN ORGAN HATI SAPI BALI SKRIPSI Diajukan untuk Melengkapi Tugas-tugas dan Memenuhi Persyaratan untuk Mencapai Gelar Sarjana Kedokteran Hewan Oleh Eva
KETERKAITAN ANTARA SIFAT FISIK EMPEDU TERHADAP KELAINAN ORGAN HATI SAPI BALI SKRIPSI Diajukan untuk Melengkapi Tugas-tugas dan Memenuhi Persyaratan untuk Mencapai Gelar Sarjana Kedokteran Hewan Oleh Eva
Struktur Histologi Dan Histomorfometri Granulosit Pada Sapi Bali Pasca Pemberian Mineral
 Buletin Veteriner Udayana Volume 8 No. 2: 151-158 pissn: 2085-2495; eissn: 2477-2712 Agustus 2016 Struktur Histologi Dan Histomorfometri Granulosit Pada Sapi Bali Pasca Pemberian Mineral (THE HISTOLOGICAL
Buletin Veteriner Udayana Volume 8 No. 2: 151-158 pissn: 2085-2495; eissn: 2477-2712 Agustus 2016 Struktur Histologi Dan Histomorfometri Granulosit Pada Sapi Bali Pasca Pemberian Mineral (THE HISTOLOGICAL
HASIL DAN PEMBAHASAN
 8 HASIL DAN PEMBAHASAN Persentase Parasitemia Menurut Ndungu et al. (2005), tingkat parasitemia diklasifikasikan menjadi tiga tingkatan, yaitu tingkat ringan (mild reaction), tingkat sedang (severe reaction),
8 HASIL DAN PEMBAHASAN Persentase Parasitemia Menurut Ndungu et al. (2005), tingkat parasitemia diklasifikasikan menjadi tiga tingkatan, yaitu tingkat ringan (mild reaction), tingkat sedang (severe reaction),
Keterkaitan antara Turbiditas Serum dan Laju Endap Darah dengan Kerusakan Hati pada Sapi Bali
 Jurnal Veteriner September 21 Vol. 11 No. 3 : 185-189 ISSN : 1411-8327 Keterkaitan antara Turbiditas Serum dan Laju Endap Darah dengan Kerusakan Hati pada Sapi Bali (THE RELATIONSHIP AMONG SERUM TURBIDITY
Jurnal Veteriner September 21 Vol. 11 No. 3 : 185-189 ISSN : 1411-8327 Keterkaitan antara Turbiditas Serum dan Laju Endap Darah dengan Kerusakan Hati pada Sapi Bali (THE RELATIONSHIP AMONG SERUM TURBIDITY
Tujuan Praktikum Menentukan waktu beku darah (waktu koagulasi darah) dari seekor hewan/manusia.
 A. WAKTU BEKU DARAH Tujuan Praktikum Menentukan waktu beku darah (waktu koagulasi darah) dari seekor hewan/manusia. Prinsip Darah yang keluar dari pembuluh darah akan berubah sifatnya, ialah dari sifat
A. WAKTU BEKU DARAH Tujuan Praktikum Menentukan waktu beku darah (waktu koagulasi darah) dari seekor hewan/manusia. Prinsip Darah yang keluar dari pembuluh darah akan berubah sifatnya, ialah dari sifat
STRUKTUR HISTOLOGI DAN HISTOMORFOMETRI ERITROSIT, LIMFOSIT, DAN MONOSIT SAPI BALI PASCA PEMBERIAN MINERAL
 RIWAYAT HIDUP Penulis dilahirkan di Jember pada tanggal 29 Oktober 1993. Penulis adalah anak tunggal dari pasangan Bapak Nur Yanto dan Ibu Nur Misdiyah. Penulis memulai pendidikan di Taman Kanak-Kanak
RIWAYAT HIDUP Penulis dilahirkan di Jember pada tanggal 29 Oktober 1993. Penulis adalah anak tunggal dari pasangan Bapak Nur Yanto dan Ibu Nur Misdiyah. Penulis memulai pendidikan di Taman Kanak-Kanak
Total dan Diferensial Leukosit Sapi Bali yang Terinfeksi Cysticercus Bovis Secara Eksperimental
 Total dan Diferensial Leukosit Sapi Bali yang Terinfeksi Cysticercus Bovis Secara Eksperimental TOTAL AND DIFFERENTIAL LEUCOCYTES OF BALI CATTLE EXPERIMENTALLY INFECTED WITH CYSTICERCUS BOVIS NI LUH PUTU
Total dan Diferensial Leukosit Sapi Bali yang Terinfeksi Cysticercus Bovis Secara Eksperimental TOTAL AND DIFFERENTIAL LEUCOCYTES OF BALI CATTLE EXPERIMENTALLY INFECTED WITH CYSTICERCUS BOVIS NI LUH PUTU
HASIL DAN PEMBAHASAN Jumlah Leukosit Total
 HASIL DAN PEMBAHASAN Jumlah Leukosit Total Leukosit merupakan unit yang aktif dari sistem pertahanan tubuh (Guyton 2008). Kondisi tubuh dan lingkungan yang berubah setiap saat akan mengakibatkan perubahan
HASIL DAN PEMBAHASAN Jumlah Leukosit Total Leukosit merupakan unit yang aktif dari sistem pertahanan tubuh (Guyton 2008). Kondisi tubuh dan lingkungan yang berubah setiap saat akan mengakibatkan perubahan
PEMERIKSAAN MIKROSKOPIS MALARIA BALAI LABORATORIUM KESEHATAN PROVINSI JAWA TENGAH TAHUN 2013
 PEMERIKSAAN MIKROSKOPIS MALARIA BALAI LABORATORIUM KESEHATAN PROVINSI JAWA TENGAH TAHUN 2013 TUJUAN Mampu membuat, mewarnai dan melakukan pemeriksaan mikroskpis sediaan darah malaria sesuai standar : Melakukan
PEMERIKSAAN MIKROSKOPIS MALARIA BALAI LABORATORIUM KESEHATAN PROVINSI JAWA TENGAH TAHUN 2013 TUJUAN Mampu membuat, mewarnai dan melakukan pemeriksaan mikroskpis sediaan darah malaria sesuai standar : Melakukan
ABSTRAK. Pembimbing I : Lisawati Sadeli, dr., M.Kes. Pembimbing II : Hartini Tiono, dr.
 iv ABSTRAK KESESUAIAN ANTARA MORFOLOGI ERITROSIT SEDIAAN APUS DARAH TEPI DENGAN NILAI HEMOGLOBIN DAN HEMATOKRIT PADA DARAH PENDONOR DI PALANG MERAH INDONESIA KOTA BANDUNG Alvin Senjaya, 2009 Pembimbing
iv ABSTRAK KESESUAIAN ANTARA MORFOLOGI ERITROSIT SEDIAAN APUS DARAH TEPI DENGAN NILAI HEMOGLOBIN DAN HEMATOKRIT PADA DARAH PENDONOR DI PALANG MERAH INDONESIA KOTA BANDUNG Alvin Senjaya, 2009 Pembimbing
PAPER HEMATOLOGI MENGHITUNG JUMLAH ERITROSIT
 PAPER HEMATOLOGI MENGHITUNG JUMLAH ERITROSIT OLEH: KELOMPOK I (GENAP) ANGGOTA: 1. NI NYOMAN MELINDAWATI (P07134013 002) 2. NI MADE INKI ARIANTI (P07134013 004) 3. NI KADEK SUCAHYANINGSIH (P07134013 006)
PAPER HEMATOLOGI MENGHITUNG JUMLAH ERITROSIT OLEH: KELOMPOK I (GENAP) ANGGOTA: 1. NI NYOMAN MELINDAWATI (P07134013 002) 2. NI MADE INKI ARIANTI (P07134013 004) 3. NI KADEK SUCAHYANINGSIH (P07134013 006)
HASIL DAN PEMBAHASAN
 17 HASIL DAN PEMBAHASAN Eritrosit, Hemoglobin, Hematokrit dan Indeks Eritrosit Jumlah eritrosit dalam darah dipengaruhi jumlah darah pada saat fetus, perbedaan umur, perbedaan jenis kelamin, pengaruh parturisi
17 HASIL DAN PEMBAHASAN Eritrosit, Hemoglobin, Hematokrit dan Indeks Eritrosit Jumlah eritrosit dalam darah dipengaruhi jumlah darah pada saat fetus, perbedaan umur, perbedaan jenis kelamin, pengaruh parturisi
PENGUKURAN BESAR SUDUT KUKU SAPI BALI (Measurement of the Angle Nail Bali Cattle) ABSTRAK
 Indonesia Medicus Veterinus Januari 1 5(1) : 3- PENGUKURAN BESAR SUDUT KUKU SAPI BALI (Measurement of the Angle Nail Bali Cattle) Anggi Windo Marta 1, Sri Kayati Widyastuti, Iwan Harjono Utama 3 1 Mahasiswa
Indonesia Medicus Veterinus Januari 1 5(1) : 3- PENGUKURAN BESAR SUDUT KUKU SAPI BALI (Measurement of the Angle Nail Bali Cattle) Anggi Windo Marta 1, Sri Kayati Widyastuti, Iwan Harjono Utama 3 1 Mahasiswa
ABSTRAK. Kata kunci : Prevalensi, Intensitas, Leucocytozoon sp., Ayam buras, Bukit Jimbaran.
 ABSTRAK Leucocytozoonosis merupakan salah satu penyakit yang sering menyebabkan kerugian berarti dalam industri peternakan. Kejadian penyakit Leucocytozoonosis dipengaruhi oleh berbagai faktor yaitu umur,
ABSTRAK Leucocytozoonosis merupakan salah satu penyakit yang sering menyebabkan kerugian berarti dalam industri peternakan. Kejadian penyakit Leucocytozoonosis dipengaruhi oleh berbagai faktor yaitu umur,
PEWARNAAN HAPUSAN DARAH TEPI. Oleh, Kelompok 2: I Gusti Agung Ayu Krisma D. D (P ) I Putu Paramartha Wicaksana A.
 PEWARNAAN HAPUSAN DARAH TEPI Oleh, Kelompok 2: I Dewa Ayu Megarani (P07134012003) Ni Wayan Nursilayani (P07134012013) I Gusti Agung Ayu Krisma D. D (P07134012023) I Putu Paramartha Wicaksana A. (P07134012033)
PEWARNAAN HAPUSAN DARAH TEPI Oleh, Kelompok 2: I Dewa Ayu Megarani (P07134012003) Ni Wayan Nursilayani (P07134012013) I Gusti Agung Ayu Krisma D. D (P07134012023) I Putu Paramartha Wicaksana A. (P07134012033)
B A B II TINJAUAN PUSTAKA. penting dari sistem transport dan bagian penting
 B A B II TINJAUAN PUSTAKA A. Tinjauan Umum Darah 1. Definisi Darah. Darah merupakan bagian penting dari sistem transport dan bagian penting dari tubuh yang jumlahnya 6 8 % dari berat badan total. Darah
B A B II TINJAUAN PUSTAKA A. Tinjauan Umum Darah 1. Definisi Darah. Darah merupakan bagian penting dari sistem transport dan bagian penting dari tubuh yang jumlahnya 6 8 % dari berat badan total. Darah
BAB I PENDAHULUAN. 1.1 Latar Belakang
 BAB I PENDAHULUAN 1.1 Latar Belakang Sel darah merah atau eritrosit merupakan sel yang paling sederhana yang ada di dalam tubuh. Eritrosit tidak memiliki nukleus dan merupakan sel terbanyak dalam darah.
BAB I PENDAHULUAN 1.1 Latar Belakang Sel darah merah atau eritrosit merupakan sel yang paling sederhana yang ada di dalam tubuh. Eritrosit tidak memiliki nukleus dan merupakan sel terbanyak dalam darah.
MATERI DAN METODE. Materi
 MATERI DAN METODE Lokasi dan Waktu Penelitian ini telah dilaksanakan dari bulan April sampai dengan bulan Mei 2011, bertempat di kandang pemuliaan ternak, Departemen Ilmu Produksi dan Teknologi Peternakan,
MATERI DAN METODE Lokasi dan Waktu Penelitian ini telah dilaksanakan dari bulan April sampai dengan bulan Mei 2011, bertempat di kandang pemuliaan ternak, Departemen Ilmu Produksi dan Teknologi Peternakan,
Ruswantriani, Pembimbing : Penny Setyawati, dr, SpPK, M. Kes
 ABSTRAK GAMBARAN LABORA TORIUM ANEMIA DEFISIENSI NUTRISI (STUDI PUST AKA) Ruswantriani, 2005. Pembimbing : Penny Setyawati, dr, SpPK, M. Kes Anemia merupakan masalah kesehatan dunia dan cenderung meningkat
ABSTRAK GAMBARAN LABORA TORIUM ANEMIA DEFISIENSI NUTRISI (STUDI PUST AKA) Ruswantriani, 2005. Pembimbing : Penny Setyawati, dr, SpPK, M. Kes Anemia merupakan masalah kesehatan dunia dan cenderung meningkat
BAB III METODE PENELITIAN
 BAB III METODE PENELITIAN 3.1. Tempat dan Waktu Penelitian ini telah dilaksanakan di kandang Fapet Farm dan analisis proksimat bahan pakan dan pemeriksaan darah dilaksanakan di Laboratorium Fakultas Peternakan
BAB III METODE PENELITIAN 3.1. Tempat dan Waktu Penelitian ini telah dilaksanakan di kandang Fapet Farm dan analisis proksimat bahan pakan dan pemeriksaan darah dilaksanakan di Laboratorium Fakultas Peternakan
RENCANA PROGRAM KEGIATAN PEMBELAJARAN SEMESTER (RPKPS)
 RENCANA PROGRAM KEGIATAN PEMBELAJARAN SEMESTER (RPKPS) Nama mata kuliah : HEMATOLOGI VETERINER Kode/SKS : Patologi Klinik Veteriner (KH-354/SKS 3/1) Prasarat : MK. Biokimia (KH-220) MK. Patologi Umum (KH--350)
RENCANA PROGRAM KEGIATAN PEMBELAJARAN SEMESTER (RPKPS) Nama mata kuliah : HEMATOLOGI VETERINER Kode/SKS : Patologi Klinik Veteriner (KH-354/SKS 3/1) Prasarat : MK. Biokimia (KH-220) MK. Patologi Umum (KH--350)
TOTAL LEUKOSIT DAN DIFERENSIASINYA PADA KAMBING PERANAKAN ETAWA (Capra aegagrus hircus) DI CARIU, BOGOR DAN CIPANAS-CIANJUR, JAWA BARAT
 TOTAL LEUKOSIT DAN DIFERENSIASINYA PADA KAMBING PERANAKAN ETAWA (Capra aegagrus hircus) DI CARIU, BOGOR DAN CIPANAS-CIANJUR, JAWA BARAT NURUL HAYYA HAFIZHIAH FAKULTAS KEDOKTERAN HEWAN INSTITUT PERTANIAN
TOTAL LEUKOSIT DAN DIFERENSIASINYA PADA KAMBING PERANAKAN ETAWA (Capra aegagrus hircus) DI CARIU, BOGOR DAN CIPANAS-CIANJUR, JAWA BARAT NURUL HAYYA HAFIZHIAH FAKULTAS KEDOKTERAN HEWAN INSTITUT PERTANIAN
PERBANDINGAN KADAR RET HE, FE, DAN TIBC PADA PENDERITA ANEMIA DEFISIENSI FE DENGAN ANEMIA KARENA PENYAKIT KRONIS
 PERBANDINGAN KADAR RET HE, FE, DAN TIBC PADA PENDERITA ANEMIA DEFISIENSI FE DENGAN ANEMIA KARENA PENYAKIT KRONIS ABSTRAK Renaldi Fakultas Kedokteran Universitas Kristen Maranatha Bandung Latar belakang
PERBANDINGAN KADAR RET HE, FE, DAN TIBC PADA PENDERITA ANEMIA DEFISIENSI FE DENGAN ANEMIA KARENA PENYAKIT KRONIS ABSTRAK Renaldi Fakultas Kedokteran Universitas Kristen Maranatha Bandung Latar belakang
KETERANDALAN PITA DALTON UNTUK MENDUGA BOBOT HIDUP KERBAU LUMPUR, SAPI BALI DAN BABI PERSILANGAN LANDRACE
 KETERANDALAN PITA DALTON UNTUK MENDUGA BOBOT HIDUP KERBAU LUMPUR, SAPI BALI DAN BABI PERSILANGAN LANDRACE I.G.M. PUTRA Jurusan Produksi Ternak, Fakultas Peternakan Universitas Udayana, Denpasar RINGKASAN
KETERANDALAN PITA DALTON UNTUK MENDUGA BOBOT HIDUP KERBAU LUMPUR, SAPI BALI DAN BABI PERSILANGAN LANDRACE I.G.M. PUTRA Jurusan Produksi Ternak, Fakultas Peternakan Universitas Udayana, Denpasar RINGKASAN
Indek Eritrosit (MCV, MCH, & MCHC)
 Indek (MCV, MCH, & MCHC) Pemeriksaan Darah Lengkap (Complete Blood Count / CBC) yaitu suatu jenis pemeriksaaan penyaring untuk menunjang diagnosa suatu penyakit dan atau untuk melihat bagaimana respon
Indek (MCV, MCH, & MCHC) Pemeriksaan Darah Lengkap (Complete Blood Count / CBC) yaitu suatu jenis pemeriksaaan penyaring untuk menunjang diagnosa suatu penyakit dan atau untuk melihat bagaimana respon
Curriculum vitae Riwayat Pendidikan: Riwayat Pekerjaan
 Curriculum vitae Nama : AA G Sudewa Djelantik Tempat/tgl lahir : Karangasem/ 24 Juli 1944 Jenis Kelamin : Laki-laki Alamat : Jln Natuna 9 Denpasar Bali Istri : Dewi Indrawati Anak : AAAyu Dewindra Djelantik
Curriculum vitae Nama : AA G Sudewa Djelantik Tempat/tgl lahir : Karangasem/ 24 Juli 1944 Jenis Kelamin : Laki-laki Alamat : Jln Natuna 9 Denpasar Bali Istri : Dewi Indrawati Anak : AAAyu Dewindra Djelantik
Kelainan darah pada Lupus eritematosus sistemik
 Kelainan darah pada Lupus eritematosus sistemik Amaylia Oehadian Sub Bagian Hematologi Onkologi Medik Bagian Penyakit Dalam Rumah Sakit Hasan Sadikin Bandung Kelainan darah pada lupus Komponen darah Kelainan
Kelainan darah pada Lupus eritematosus sistemik Amaylia Oehadian Sub Bagian Hematologi Onkologi Medik Bagian Penyakit Dalam Rumah Sakit Hasan Sadikin Bandung Kelainan darah pada lupus Komponen darah Kelainan
Pengaruh Vitamin E Tokotrienol dan Gabungannya dengan Asam Askorbat Terhadap Jumlah dan Jenis Leukosit Tikus Putih (Rattus norvegicus L.
 Pengaruh Vitamin E Tokotrienol dan Gabungannya dengan Asam Askorbat Terhadap Jumlah dan Jenis Leukosit Tikus Putih (Rattus norvegicus L.) TESIS Diajukan kepada Program Studi Magister Biologi, Fakultas
Pengaruh Vitamin E Tokotrienol dan Gabungannya dengan Asam Askorbat Terhadap Jumlah dan Jenis Leukosit Tikus Putih (Rattus norvegicus L.) TESIS Diajukan kepada Program Studi Magister Biologi, Fakultas
ABSTRAK. Kata kunci: sapi bali, dermatofitosis, leukosit.
 RIWAYAT HIDUP Penulis dilahirkan di Jember, Jawa Timur pada tanggal 17 Oktober 1992, merupakan anak pertama dari tiga bersaudara pasangan dari Bapak Bambang Eko Nurcahyono dan Ibu Dwi Wiwik Aning Rahayu,
RIWAYAT HIDUP Penulis dilahirkan di Jember, Jawa Timur pada tanggal 17 Oktober 1992, merupakan anak pertama dari tiga bersaudara pasangan dari Bapak Bambang Eko Nurcahyono dan Ibu Dwi Wiwik Aning Rahayu,
Dinamika Leukosit Akibat Xilazin pada Anjing Lokal yang Dianestesi Ketamin secara Subkutan
 Dinamika Leukosit Akibat Xilazin pada Anjing Lokal yang Dianestesi Ketamin secara Subkutan (DYNAMICS OF LEUKOCYTE AFFECTED BY XYLAZINE ON LOCAL DOGS ANESTHETIZED WITH KETAMINE SUBCUTANEOUSLY) Komang Sri
Dinamika Leukosit Akibat Xilazin pada Anjing Lokal yang Dianestesi Ketamin secara Subkutan (DYNAMICS OF LEUKOCYTE AFFECTED BY XYLAZINE ON LOCAL DOGS ANESTHETIZED WITH KETAMINE SUBCUTANEOUSLY) Komang Sri
BAB II TINJAUAN PUSTAKA. Sel darah putih ( lekosit ) rupanya bening dan tidak berwarna, bentuknya lebih besar
 BAB II TINJAUAN PUSTAKA 1. Pengertian Lekosit Sel darah putih ( lekosit ) rupanya bening dan tidak berwarna, bentuknya lebih besar dari sel darah merah, tetapi jumlah sel darah putih lebih sedikit. Diameter
BAB II TINJAUAN PUSTAKA 1. Pengertian Lekosit Sel darah putih ( lekosit ) rupanya bening dan tidak berwarna, bentuknya lebih besar dari sel darah merah, tetapi jumlah sel darah putih lebih sedikit. Diameter
JURNAL KESEHATAN RAJAWALI
 Volume 5, Nomor 9, Oktober 2015 ISSN 2085-7764 JURNAL KESEHATAN RAJAWALI Jurnal Ilmu-Ilmu Kesehatan JURNAL ENAM BULANAN Hubungan Cara Menyusui Dengan Kejadian Payudara Bengkak Pada Ibu Nifas Di Puskesmas
Volume 5, Nomor 9, Oktober 2015 ISSN 2085-7764 JURNAL KESEHATAN RAJAWALI Jurnal Ilmu-Ilmu Kesehatan JURNAL ENAM BULANAN Hubungan Cara Menyusui Dengan Kejadian Payudara Bengkak Pada Ibu Nifas Di Puskesmas
TOTAL DAN DIFERENSIAL LEUKOSIT BABI LANDRACE YANG DIBERI PAKAN ECENG GONDOK (Eichornia crassipes) DARI PERAIRAN TERCEMAR TIMBAL (Pb) SKRIPSI
 TOTAL DAN DIFERENSIAL LEUKOSIT BABI LANDRACE YANG DIBERI PAKAN ECENG GONDOK (Eichornia crassipes) DARI PERAIRAN TERCEMAR TIMBAL (Pb) SKRIPSI Diajukan untuk Melengkapi Tugas Tugas dan Memenuhi Persyaratan
TOTAL DAN DIFERENSIAL LEUKOSIT BABI LANDRACE YANG DIBERI PAKAN ECENG GONDOK (Eichornia crassipes) DARI PERAIRAN TERCEMAR TIMBAL (Pb) SKRIPSI Diajukan untuk Melengkapi Tugas Tugas dan Memenuhi Persyaratan
HASIL DAN PEMBAHASAN
 10 kemudian dicuci dengan air mengalir untuk menghilangkan sisa zat warna lalu dikeringkan. Selanjutnya, DPX mountant diteteskan pada preparat ulas darah tersebut, ditutup dengan cover glass dan didiamkan
10 kemudian dicuci dengan air mengalir untuk menghilangkan sisa zat warna lalu dikeringkan. Selanjutnya, DPX mountant diteteskan pada preparat ulas darah tersebut, ditutup dengan cover glass dan didiamkan
PEMERIKSAAN LAJU ENDAP DARAH (LED) SEBAGAI INDIKATOR TERHADAP ABNORMALITAS ORGAN HATI KAMBING LOKAL
 Jois Jacob dan Yanse Rumlaklak, Pemeriksaan Laju Endap Darah (LED) sebagai 13 PEMERIKSAAN LAJU ENDAP DARAH (LED) SEBAGAI INDIKATOR TERHADAP ABNORMALITAS ORGAN HATI KAMBING LOKAL Jois M. Jacob dan Yanse
Jois Jacob dan Yanse Rumlaklak, Pemeriksaan Laju Endap Darah (LED) sebagai 13 PEMERIKSAAN LAJU ENDAP DARAH (LED) SEBAGAI INDIKATOR TERHADAP ABNORMALITAS ORGAN HATI KAMBING LOKAL Jois M. Jacob dan Yanse
BAB IV HASIL DAN PEMBAHASAN. rawat inap di RSU & Holistik Sejahtera Bhakti Kota Salatiga. kanker payudara positif dan di duga kanker payudara.
 BAB IV HASIL DAN PEMBAHASAN A. Gambaran Umum Penelitian Penelitian dilakukan di Laboratorium RSU & Holistik Sejahtera Bhakti Kota Salatiga pada bulan Desember 2012 - Februari 2013. Jumlah sampel yang diambil
BAB IV HASIL DAN PEMBAHASAN A. Gambaran Umum Penelitian Penelitian dilakukan di Laboratorium RSU & Holistik Sejahtera Bhakti Kota Salatiga pada bulan Desember 2012 - Februari 2013. Jumlah sampel yang diambil
Jurnal Kajian Veteriner Volume 3 Nomor 1 : ISSN: Gambaran Hematologi pada Rusa Timor (Cervus timorensis)
 Gambaran Hematologi pada Rusa Timor (Cervus timorensis) (Hematologic Description of Timor Deer (Cervus timorensis) Yanse Yane Rumlaklak 1) dan Novianti Neliyani Toelle 1) 1) Program Studi Kesehatan Hewan,
Gambaran Hematologi pada Rusa Timor (Cervus timorensis) (Hematologic Description of Timor Deer (Cervus timorensis) Yanse Yane Rumlaklak 1) dan Novianti Neliyani Toelle 1) 1) Program Studi Kesehatan Hewan,
SCREENING IBR DAN DIFERENSIAL LEUKOSIT UNTUK PENGENDALIAN GANGGUAN REPRODUKSI SAPI PO DI DAERAH INTEGRASI JAGUNG-SAPI. Bogor, 8-9 Agustus 2017
 SCREENING IBR DAN DIFERENSIAL LEUKOSIT UNTUK PENGENDALIAN GANGGUAN REPRODUKSI SAPI PO DI DAERAH INTEGRASI JAGUNG-SAPI Bogor, 8-9 Agustus 2017 Latar Belakang Pertambahan populasi lambat Penurunan performa
SCREENING IBR DAN DIFERENSIAL LEUKOSIT UNTUK PENGENDALIAN GANGGUAN REPRODUKSI SAPI PO DI DAERAH INTEGRASI JAGUNG-SAPI Bogor, 8-9 Agustus 2017 Latar Belakang Pertambahan populasi lambat Penurunan performa
PEMBERIAN BERBAGAI DOSIS PREMEDIKASI XILAZIN PADA ANJING LOKAL YANG DIANESTESI KETAMIN SECARA SUBKUTAN TERHADAP GAMBARAN LEUKOSIT SKRIPSI
 PEMBERIAN BERBAGAI DOSIS PREMEDIKASI XILAZIN PADA ANJING LOKAL YANG DIANESTESI KETAMIN SECARA SUBKUTAN TERHADAP GAMBARAN LEUKOSIT SKRIPSI Oleh Komang Sri Adiari NIM. 1009005059 FAKULTAS KEDOKTERAN HEWAN
PEMBERIAN BERBAGAI DOSIS PREMEDIKASI XILAZIN PADA ANJING LOKAL YANG DIANESTESI KETAMIN SECARA SUBKUTAN TERHADAP GAMBARAN LEUKOSIT SKRIPSI Oleh Komang Sri Adiari NIM. 1009005059 FAKULTAS KEDOKTERAN HEWAN
Keterampilan Laboratorium PADA BLOK 2.2 HEMATOIMUNOLIMFOPOETIK:
 Keterampilan Laboratorium PADA BLOK 2.2 HEMATOIMUNOLIMFOPOETIK: DARAH 2: -LED -Membuat & memeriksa sediaan apus darah tepi -Evaluasi DARAH 3: - Pemeriksaan gol.darah -Tes inkompatibilitas DARAH 4: Bleeding
Keterampilan Laboratorium PADA BLOK 2.2 HEMATOIMUNOLIMFOPOETIK: DARAH 2: -LED -Membuat & memeriksa sediaan apus darah tepi -Evaluasi DARAH 3: - Pemeriksaan gol.darah -Tes inkompatibilitas DARAH 4: Bleeding
III. METODE PENELITIAN
 III. METODE PENELITIAN Alat dan Bahan Alat-alat yang digunakan untuk pengambilan sampel darah yaitu obyek glass, cover glass, Haemicitometer, jarum suntik, pipet kapiler, mikroskop monokuler. Vitamin E
III. METODE PENELITIAN Alat dan Bahan Alat-alat yang digunakan untuk pengambilan sampel darah yaitu obyek glass, cover glass, Haemicitometer, jarum suntik, pipet kapiler, mikroskop monokuler. Vitamin E
Kata kunci: Fascioliosis, total eritrosit, kadar hemoglobin,pakced cell voleme, Sapi Bali
 ABSTRAK Fascioliosis pada sapi di Indonesia disebabkan oleh cacing Fasciola gigantica yang berpredileksi di saluran empedu dan hati. Infeksi cacing ini menyebabkan gangguan fungsi hati dan kerusakan saluran
ABSTRAK Fascioliosis pada sapi di Indonesia disebabkan oleh cacing Fasciola gigantica yang berpredileksi di saluran empedu dan hati. Infeksi cacing ini menyebabkan gangguan fungsi hati dan kerusakan saluran
BAB III METODE PENELITIAN
 BAB III METODE PENELITIAN A. Jenis Penelitian Jenis penelitian ini adalah analitik karena mencari perbedaan antara dua variabel yaitu perbedaan darah lengkap kanker payudara positif dan diduga kanker payudara.
BAB III METODE PENELITIAN A. Jenis Penelitian Jenis penelitian ini adalah analitik karena mencari perbedaan antara dua variabel yaitu perbedaan darah lengkap kanker payudara positif dan diduga kanker payudara.
OLEH JURUSAN BIOLOGI FAKULTAS MATEMATIKA DAN ILMU PENGETAHUAN ALAM UNIVERSITAS HALU OLEO KENDARI
 LAPORAN PRAKTIKUM MIKROTEKNIK PRAKTIKUM I PREPARAT APUS (SMEAR PREPARATION) OLEH NAMA : I WAYAN RUSTANTO NIM : F1D1 12 039 KELOMPOK : 3 (TIGA) ASISTEN PEMBIMBING : FATMA CAHYA PUTRI JURUSAN BIOLOGI FAKULTAS
LAPORAN PRAKTIKUM MIKROTEKNIK PRAKTIKUM I PREPARAT APUS (SMEAR PREPARATION) OLEH NAMA : I WAYAN RUSTANTO NIM : F1D1 12 039 KELOMPOK : 3 (TIGA) ASISTEN PEMBIMBING : FATMA CAHYA PUTRI JURUSAN BIOLOGI FAKULTAS
HASIL DAN PEMBAHASAN
 HASIL DAN PEMBAHASAN Gambaran darah berupa jumlah eritrosit, konsentrasi hemoglobin, dan nilai hematokrit sapi perah FH umur satu sampai dua belas bulan ditampilkan pada Tabel 3. Tabel 3 Gambaran Eritrosit
HASIL DAN PEMBAHASAN Gambaran darah berupa jumlah eritrosit, konsentrasi hemoglobin, dan nilai hematokrit sapi perah FH umur satu sampai dua belas bulan ditampilkan pada Tabel 3. Tabel 3 Gambaran Eritrosit
ABSTRAK PERBANDINGAN KADAR RET HE, FE, DAN TIBC PADA PENDERITA ANEMIA DEFISIENSI FE DENGAN ANEMIA KARENA PENYAKIT KRONIS
 ABSTRAK PERBANDINGAN KADAR RET HE, FE, DAN TIBC PADA PENDERITA ANEMIA DEFISIENSI FE DENGAN ANEMIA KARENA PENYAKIT KRONIS Renaldi, 2013 Pembimbing I : dr. Fenny, Sp.PK., M.Kes Pembimbing II : dr. Indahwaty,
ABSTRAK PERBANDINGAN KADAR RET HE, FE, DAN TIBC PADA PENDERITA ANEMIA DEFISIENSI FE DENGAN ANEMIA KARENA PENYAKIT KRONIS Renaldi, 2013 Pembimbing I : dr. Fenny, Sp.PK., M.Kes Pembimbing II : dr. Indahwaty,
Gambaran Ulas Darah Ikan Lele Di Denpasar Bali
 Gambaran Ulas Darah Ikan Lele Di Denpasar Bali (PICTURE OF THE REVIEW OF CATFISH IN BALI) Chanda Preanger 1, Iwan Harjono Utama 2, I Made Kardena 3 1. Mahasiswa Program Dokter Hewan 2. Laboratorium Biokimia
Gambaran Ulas Darah Ikan Lele Di Denpasar Bali (PICTURE OF THE REVIEW OF CATFISH IN BALI) Chanda Preanger 1, Iwan Harjono Utama 2, I Made Kardena 3 1. Mahasiswa Program Dokter Hewan 2. Laboratorium Biokimia
Pola Gambaran Darah Tepi pada Penderita Leukimia di Laboratorium Klinik RSUP Dr. Mohammad Hoesin Palembang
 Pola Gambaran Darah Tepi pada Penderita Leukimia di Laboratorium Klinik RSUP Dr. Mohammad Hoesin Palembang Kemas Ya kub Rahadiyanto 1, Phey Liana 1, Baity Indriani 1 1. Bagian Patologi Klinik, Fakultas
Pola Gambaran Darah Tepi pada Penderita Leukimia di Laboratorium Klinik RSUP Dr. Mohammad Hoesin Palembang Kemas Ya kub Rahadiyanto 1, Phey Liana 1, Baity Indriani 1 1. Bagian Patologi Klinik, Fakultas
HASIL DAN PEMBAHASAN
 HASIL DAN PEMBAHASAN Identifikasi dan Persentase Parasit Darah Hasil pengamatan preparat ulas darah pada enam ekor kuda yang berada di Unit Rehabilitasi Reproduksi (URR FKH IPB) dapat dilihat sebagai berikut
HASIL DAN PEMBAHASAN Identifikasi dan Persentase Parasit Darah Hasil pengamatan preparat ulas darah pada enam ekor kuda yang berada di Unit Rehabilitasi Reproduksi (URR FKH IPB) dapat dilihat sebagai berikut
PERBANDINGAN PEMERIKSAAN HITUNG JENIS LEUKOSIT DENGAN PEWARNAAN KOMBINASI GIEMSA DAN WRIGHT
 PERBANDINGAN PEMERIKSAAN HITUNG JENIS LEUKOSIT DENGAN PEWARNAAN KOMBINASI GIEMSA DAN WRIGHT Chandra Nurlaela *, Dewi Yayuningsih, Siti Sa adah Alawiyah Program Studi Diploma III Analis Kesehatan STIKes
PERBANDINGAN PEMERIKSAAN HITUNG JENIS LEUKOSIT DENGAN PEWARNAAN KOMBINASI GIEMSA DAN WRIGHT Chandra Nurlaela *, Dewi Yayuningsih, Siti Sa adah Alawiyah Program Studi Diploma III Analis Kesehatan STIKes
PENGARUH PEMBERIAN PARACETAMOL DALAM PAKAN TERHADAP GAMBARAN DARAH (TOTAL LEUKOSIT DAN DIFERENSIAL LEUKOSIT) AYAM PEDAGING SKRIPSI
 PENGARUH PEMBERIAN PARACETAMOL DALAM PAKAN TERHADAP GAMBARAN DARAH (TOTAL LEUKOSIT DAN DIFERENSIAL LEUKOSIT) AYAM PEDAGING SKRIPSI Diajukan untuk Melengkapi Tugas-Tugas dan Memenuhi Persyaratan untuk Mencapai
PENGARUH PEMBERIAN PARACETAMOL DALAM PAKAN TERHADAP GAMBARAN DARAH (TOTAL LEUKOSIT DAN DIFERENSIAL LEUKOSIT) AYAM PEDAGING SKRIPSI Diajukan untuk Melengkapi Tugas-Tugas dan Memenuhi Persyaratan untuk Mencapai
Total Eritrosit, Hemoglobin, Pack Cell Volume, dan Indeks Eritrosit Sapi Bali yang Terinfeksi Cysticercus Bovis
 Total Eritrosit, Hemoglobin, Pack Cell Volume, dan Indeks Eritrosit Sapi Bali yang Terinfeksi Cysticercus Bovis ERYTHROCYTES TOTAL, HEMOGLOBIN, PACK CELL VOLUME, AND ERYTHROCYTES INDEX OF BALI CATTLE INFECTED
Total Eritrosit, Hemoglobin, Pack Cell Volume, dan Indeks Eritrosit Sapi Bali yang Terinfeksi Cysticercus Bovis ERYTHROCYTES TOTAL, HEMOGLOBIN, PACK CELL VOLUME, AND ERYTHROCYTES INDEX OF BALI CATTLE INFECTED
ABSTRAK MORFOLOGI ERITROSIT PADA SEDIAAN APUS DARAH TEPI (SADT) SAMPEL DENGAN HASIL PEMERIKSAAN ONE TUBE OSMOTIC FRAGILITY TEST (OTOFT) POSITIF
 ABSTRAK MORFOLOGI ERITROSIT PADA SEDIAAN APUS DARAH TEPI (SADT) SAMPEL DENGAN HASIL PEMERIKSAAN ONE TUBE OSMOTIC FRAGILITY TEST (OTOFT) POSITIF Muhammad Chalid Ghozali Daulay, 2010 Pembimbing I : Christine
ABSTRAK MORFOLOGI ERITROSIT PADA SEDIAAN APUS DARAH TEPI (SADT) SAMPEL DENGAN HASIL PEMERIKSAAN ONE TUBE OSMOTIC FRAGILITY TEST (OTOFT) POSITIF Muhammad Chalid Ghozali Daulay, 2010 Pembimbing I : Christine
I. PENDAHULUAN Latar Belakang
 I. PENDAHULUAN Latar Belakang Tubuh manusia secara fisiologis memiliki sistim pertahanan utama untuk melawan radikal bebas, yaitu antioksidan yang berupa enzim dan nonenzim. Antioksidan enzimatik bekerja
I. PENDAHULUAN Latar Belakang Tubuh manusia secara fisiologis memiliki sistim pertahanan utama untuk melawan radikal bebas, yaitu antioksidan yang berupa enzim dan nonenzim. Antioksidan enzimatik bekerja
BAB II TINJAUAN PUSTAKA. Darah adalah suspensi dari partikel dalam larutan koloid cair yang
 BAB II TINJAUAN PUSTAKA A. Darah 1. Definisi Darah adalah suspensi dari partikel dalam larutan koloid cair yang mengandung elektrolit. Peranannya sebagai medium pertukaran antara sel-sel yang terfiksasi
BAB II TINJAUAN PUSTAKA A. Darah 1. Definisi Darah adalah suspensi dari partikel dalam larutan koloid cair yang mengandung elektrolit. Peranannya sebagai medium pertukaran antara sel-sel yang terfiksasi
IMUNITAS NON-SPESIFIK DAN SINTASAN LELE MASAMO (Clarias sp.) DENGAN APLIKASI PROBIOTIK, VITAMIN C DAN DASAR KOLAM BUATAN ABSTRAK
 e-jurnal Rekayasa dan Teknologi Budidaya Perairan Volume IV No 2 Februari 2016 ISSN: 2302-3600 IMUNITAS NON-SPESIFIK DAN SINTASAN LELE MASAMO (Clarias sp.) DENGAN APLIKASI PROBIOTIK, VITAMIN C DAN DASAR
e-jurnal Rekayasa dan Teknologi Budidaya Perairan Volume IV No 2 Februari 2016 ISSN: 2302-3600 IMUNITAS NON-SPESIFIK DAN SINTASAN LELE MASAMO (Clarias sp.) DENGAN APLIKASI PROBIOTIK, VITAMIN C DAN DASAR
Gambaran Diff Count Pada Perokok Di Kecamatan Cibeureum. Undang Ruhimat STIKes Bakti Tunas Husada Tasikmalaya ABSTRAK
 Gambaran Diff Count Pada Perokok Di Kecamatan Cibeureum Undang Ruhimat STIKes Bakti Tunas Husada Tasikmalaya ABSTRAK Keberadaan zat-zat beracun dari asap rokok menyebabkan tubuh melakukan perlawanan terhadap
Gambaran Diff Count Pada Perokok Di Kecamatan Cibeureum Undang Ruhimat STIKes Bakti Tunas Husada Tasikmalaya ABSTRAK Keberadaan zat-zat beracun dari asap rokok menyebabkan tubuh melakukan perlawanan terhadap
LAPORAN PRAKTIKUM HEMATOLOGI PEMBUATAN DAN PEWARNAAN SEDIAAN APUSAN DARAH
 LAPORAN PRAKTIKUM HEMATOLOGI PEMBUATAN DAN PEWARNAAN SEDIAAN APUSAN DARAH I. Tujuan Untuk dapat mengetahui cara pembuatan dan pewarnaan sediaan hapusan darah II. Metode Hapusan darah ( blood smear ) III.
LAPORAN PRAKTIKUM HEMATOLOGI PEMBUATAN DAN PEWARNAAN SEDIAAN APUSAN DARAH I. Tujuan Untuk dapat mengetahui cara pembuatan dan pewarnaan sediaan hapusan darah II. Metode Hapusan darah ( blood smear ) III.
BAHAYA AKIBAT LEUKOSIT TINGGI
 1 BAHAYA AKIBAT LEUKOSIT TINGGI TUGAS I Disusun untuk memenuhi tugas praktikum brosing artikel dari internet HaloSehat.com Editor SHOBIBA TURROHMAH NIM: G0C015075 PROGRAM DIPLOMA III ANALIS KESEHATAN FAKULTAS
1 BAHAYA AKIBAT LEUKOSIT TINGGI TUGAS I Disusun untuk memenuhi tugas praktikum brosing artikel dari internet HaloSehat.com Editor SHOBIBA TURROHMAH NIM: G0C015075 PROGRAM DIPLOMA III ANALIS KESEHATAN FAKULTAS
BAB III METODE PENELITIAN. Ruang lingkup penelitian ini adalah ilmu farmakologi dan imunologi.
 BAB III METODE PENELITIAN 3.1 Ruang Lingkup Penelitian Ruang lingkup penelitian ini adalah ilmu farmakologi dan imunologi. 3.2 Tempat dan Waktu Penelitian Perawatan tikus dan pemberian perlakuan dilakukan
BAB III METODE PENELITIAN 3.1 Ruang Lingkup Penelitian Ruang lingkup penelitian ini adalah ilmu farmakologi dan imunologi. 3.2 Tempat dan Waktu Penelitian Perawatan tikus dan pemberian perlakuan dilakukan
BAB I PENDAHULUAN. laboratorium dituntut untuk memberikan hasil yang tepat, cepat dan akurat.
 BAB I PENDAHULUAN 1.1 Latar Belakang Laboratorium klinik merupakan bagian yang tidak dapat terpisahkan dari pelayanan kesehatan karenamenempati posisi penting dalam diagnosis invitro. Hal ini beralasan,
BAB I PENDAHULUAN 1.1 Latar Belakang Laboratorium klinik merupakan bagian yang tidak dapat terpisahkan dari pelayanan kesehatan karenamenempati posisi penting dalam diagnosis invitro. Hal ini beralasan,
BAB I PENDAHULUAN. sediaan mikroteknik atau yang juga dikenal sebagai sediaan Histologi.
 1 BAB I PENDAHULUAN 1.1 Latar Belakang Perkembangan pengetahuan mengenai anatomi mikroskopis baik tentang hewan maupun tumbuhan banyak diperoleh dari hasil pengembangan sediaan mikroteknik atau yang juga
1 BAB I PENDAHULUAN 1.1 Latar Belakang Perkembangan pengetahuan mengenai anatomi mikroskopis baik tentang hewan maupun tumbuhan banyak diperoleh dari hasil pengembangan sediaan mikroteknik atau yang juga
BAB III MATERI DAN METODE. Penelitian ini dilaksanakan sejak bulan Mei sampai dengan Juli 2016,
 14 BAB III MATERI DAN METODE Penelitian ini dilaksanakan sejak bulan Mei sampai dengan Juli 2016, pemeliharaan ayam broiler dilaksanakan selama 28 hari di Laboratorium Produksi Ternak Unggas Fakultas Peternakan
14 BAB III MATERI DAN METODE Penelitian ini dilaksanakan sejak bulan Mei sampai dengan Juli 2016, pemeliharaan ayam broiler dilaksanakan selama 28 hari di Laboratorium Produksi Ternak Unggas Fakultas Peternakan
ABSTRACT PENDAHULUAN SOSIALISASI FLU BURUNG SERTA PEMERIKSAAN JUMLAH SEL DARAH PUTIH DAN TROMBOSIT PENDUDUK DESA BERABAN KABUPATEN TABANAN
 SOSIALISASI FLU BURUNG SERTA PEMERIKSAAN JUMLAH SEL DARAH PUTIH DAN TROMBOSIT PENDUDUK DESA BERABAN KABUPATEN TABANAN A.A.WIRADEWI LESTARI Bagian Patologi Klinik Fakultas Kedokteran Unversitas Udayana
SOSIALISASI FLU BURUNG SERTA PEMERIKSAAN JUMLAH SEL DARAH PUTIH DAN TROMBOSIT PENDUDUK DESA BERABAN KABUPATEN TABANAN A.A.WIRADEWI LESTARI Bagian Patologi Klinik Fakultas Kedokteran Unversitas Udayana
BAB V HASIL. berat badan gram. Kemudian dilakukan aklimatisasi selama 1 minggu,
 BAB V HASIL Penelitian dilakukan pada 18 ekor tikus Wistar berusia 8 minggu dengan berat badan 200-300 gram. Kemudian dilakukan aklimatisasi selama 1 minggu, dan diberikan pakan standar. Setelah itu dibagi
BAB V HASIL Penelitian dilakukan pada 18 ekor tikus Wistar berusia 8 minggu dengan berat badan 200-300 gram. Kemudian dilakukan aklimatisasi selama 1 minggu, dan diberikan pakan standar. Setelah itu dibagi
HEMATOLOGI KLINIK ANJING PENDERITA DIROFILARIASIS. Menurut Atkins (2005), anjing penderita penyakit cacing jantung
 16 HEMATOLOGI KLINIK ANJING PENDERITA DIROFILARIASIS Menurut Atkins (2005), anjing penderita penyakit cacing jantung memiliki kelainan hematologi pada tingkat ringan berupa anemia, neutrofilia, eosinofilia,
16 HEMATOLOGI KLINIK ANJING PENDERITA DIROFILARIASIS Menurut Atkins (2005), anjing penderita penyakit cacing jantung memiliki kelainan hematologi pada tingkat ringan berupa anemia, neutrofilia, eosinofilia,
BAB I PENDAHULUAN. hormon insulin baik secara relatif maupun secara absolut. Jika hal ini dibiarkan
 BAB I PENDAHULUAN 1.1. Latar Belakang Diabetes mellitus merupakan suatu penyakit menahun yang ditandai dengan adanya kadar glukosa darah yang melebihi nilai normal dan gangguan metabolisme karbohidrat,
BAB I PENDAHULUAN 1.1. Latar Belakang Diabetes mellitus merupakan suatu penyakit menahun yang ditandai dengan adanya kadar glukosa darah yang melebihi nilai normal dan gangguan metabolisme karbohidrat,
LAPORAN PRAKTIKUM ANATOMI FISIOLOGI MANUSIA SEDIAAN APUS DARAH
 LAPORAN PRAKTIKUM ANATOMI FISIOLOGI MANUSIA SEDIAAN APUS DARAH DISUSUN OLEH: Anis Rachmawati (3415080201) Fina Lidyana (3415081961) Kusfebriani (3415081962) Rani Rahmahdini (3415083253) R.A Nurhikmah Annisa
LAPORAN PRAKTIKUM ANATOMI FISIOLOGI MANUSIA SEDIAAN APUS DARAH DISUSUN OLEH: Anis Rachmawati (3415080201) Fina Lidyana (3415081961) Kusfebriani (3415081962) Rani Rahmahdini (3415083253) R.A Nurhikmah Annisa
BAB 1 PENDAHULUAN. Defisiensi besi merupakan gangguan nutrisi yang secara umum. terjadi di seluruh dunia dan mengenai lebih kurang 25% dari seluruh
 1 BAB 1 PENDAHULUAN 1.1. Latar Belakang Defisiensi besi merupakan gangguan nutrisi yang secara umum terjadi di seluruh dunia dan mengenai lebih kurang 25% dari seluruh populasi. 1 Wanita hamil merupakan
1 BAB 1 PENDAHULUAN 1.1. Latar Belakang Defisiensi besi merupakan gangguan nutrisi yang secara umum terjadi di seluruh dunia dan mengenai lebih kurang 25% dari seluruh populasi. 1 Wanita hamil merupakan
EVALUASI HASIL PEMERIKSAAN POLA HITUNG JENIS SEL DARAH PEKERJA RADIASI
M. Yazid, dkk. ISSN 6-38 EVALUASI HASIL PEMERIKSAAN POLA HITUNG JENIS SEL DARAH PEKERJA RADIASI M. Yazid, Triyono, Inggih Wigati, Zainul Kamal Puslitbang Teknologi Maju BATAN ABSTRAK EVALUASI HASIL PEMERIKSAAN
M. Yazid, dkk. ISSN 6-38 EVALUASI HASIL PEMERIKSAAN POLA HITUNG JENIS SEL DARAH PEKERJA RADIASI M. Yazid, Triyono, Inggih Wigati, Zainul Kamal Puslitbang Teknologi Maju BATAN ABSTRAK EVALUASI HASIL PEMERIKSAAN
BAB III METODE PENELITIAN
 BAB III METODE PENELITIAN A. Jenis Penelitian Penelitian ini bersifat observasional analitik dengan pendekatan cross-sectional. Yang dimaksud dengan penelitian analitik yaitu penelitian yang hasilnya tidak
BAB III METODE PENELITIAN A. Jenis Penelitian Penelitian ini bersifat observasional analitik dengan pendekatan cross-sectional. Yang dimaksud dengan penelitian analitik yaitu penelitian yang hasilnya tidak
PERBANDINGAN TINGKAT AUTOLISIS ANTARA OTOT DAN HATI SAPI BALI PADA BEBERAPA PERIODE WAKTU PENGAMATAN SKRIPSI
 i PERBANDINGAN TINGKAT AUTOLISIS ANTARA OTOT DAN HATI SAPI BALI PADA BEBERAPA PERIODE WAKTU PENGAMATAN SKRIPSI Diajukan untuk Melengkapi Tugas-tugas dan Memenuhi Persyaratan untuk Mencapai Gelar Sarjana
i PERBANDINGAN TINGKAT AUTOLISIS ANTARA OTOT DAN HATI SAPI BALI PADA BEBERAPA PERIODE WAKTU PENGAMATAN SKRIPSI Diajukan untuk Melengkapi Tugas-tugas dan Memenuhi Persyaratan untuk Mencapai Gelar Sarjana
BAB III MATERI DAN METODE. Penelitian dilaksanakan bulan Desember 2016 Januari Lokasi
 15 BAB III MATERI DAN METODE Penelitian dilaksanakan bulan Desember 2016 Januari 2017. Lokasi pemeliharaan ayam broiler di Peternakan milik Bapak Hadi Desa Sodong Kecamatan Mijen Kota Semarang. Analisis
15 BAB III MATERI DAN METODE Penelitian dilaksanakan bulan Desember 2016 Januari 2017. Lokasi pemeliharaan ayam broiler di Peternakan milik Bapak Hadi Desa Sodong Kecamatan Mijen Kota Semarang. Analisis
Pemotongan Sapi Betina Produktif di Rumah Potong Hewan di Daerah Istimewa Yogyakarta
 Sains Peternakan Vol. 7 (1), Maret 2009: 20-24 ISSN 1693-8828 Pemotongan Sapi Betina Produktif di Rumah Potong Hewan di Daerah Istimewa Yogyakarta N. Rasminati, S. Utomo dan D.A. Riyadi Jurusan Peternakan,
Sains Peternakan Vol. 7 (1), Maret 2009: 20-24 ISSN 1693-8828 Pemotongan Sapi Betina Produktif di Rumah Potong Hewan di Daerah Istimewa Yogyakarta N. Rasminati, S. Utomo dan D.A. Riyadi Jurusan Peternakan,
BAB II TINJAUAN PUSTAKA. oksigen. Darah terdiri dari bagian cair dan padat, bagian cair yaitu berupa plasma
 BAB II TINJAUAN PUSTAKA A. Darah 1. Pengertian darah Dalam system sirkulasi darah merupakan bagian penting yaitu dalam transport oksigen. Darah terdiri dari bagian cair dan padat, bagian cair yaitu berupa
BAB II TINJAUAN PUSTAKA A. Darah 1. Pengertian darah Dalam system sirkulasi darah merupakan bagian penting yaitu dalam transport oksigen. Darah terdiri dari bagian cair dan padat, bagian cair yaitu berupa
KARYA TULIS ILMIAH PROFIL JUMLAH DAN HITUNG JENIS LEUKOSIT DARAH TEPI PADA LANSIA DI PANTI SOSIAL TRESNA WERDHA KLINIS PENYAKIT
 KARYA TULIS ILMIAH PROFIL JUMLAH DAN HITUNG JENIS LEUKOSIT DARAH TEPI PADA LANSIA DI PANTI SOSIAL TRESNA WERDHA KLINIS PENYAKIT Diajukan untuk Memenuhi Sebagian Syarat Memperoleh Derajat Sarjana Kedokteran
KARYA TULIS ILMIAH PROFIL JUMLAH DAN HITUNG JENIS LEUKOSIT DARAH TEPI PADA LANSIA DI PANTI SOSIAL TRESNA WERDHA KLINIS PENYAKIT Diajukan untuk Memenuhi Sebagian Syarat Memperoleh Derajat Sarjana Kedokteran
BAB II TINJAUAN PUSTAKA. Plasma darah, merupakan bagian yang cair dan bagian korpuskuli yakni
 BAB II TINJAUAN PUSTAKA A. Darah 1. Pengertian Darah Darah merupakan bagian penting dari system transport. Darah merupakan jaringan yang berbentuk cairan yang terdiri dari dua bagian besar, yaitu: Plasma
BAB II TINJAUAN PUSTAKA A. Darah 1. Pengertian Darah Darah merupakan bagian penting dari system transport. Darah merupakan jaringan yang berbentuk cairan yang terdiri dari dua bagian besar, yaitu: Plasma
Bila Darah Disentifus
 Judul Fungsi Darah Bila Darah Disentifus Terdiri dari 3 lapisan yaitu : Darah di sentrifuse q Lapis paling bawah (merah) 45% adalah Eritrosit atau hematokrit q Lapis tengah (abu-abu putih) 1 % adalah
Judul Fungsi Darah Bila Darah Disentifus Terdiri dari 3 lapisan yaitu : Darah di sentrifuse q Lapis paling bawah (merah) 45% adalah Eritrosit atau hematokrit q Lapis tengah (abu-abu putih) 1 % adalah
BAB II TINJAUAN PUSTAKA. sisanya terdiri dari sel darah. ( Evelyn C. Pearce, 2006 ) sedang keberadaannya dalam darah, hanya melintas saja.
 BAB II TINJAUAN PUSTAKA A. Darah Darah adalah jaringan cair yang terdiri atas dua bagian yaitu plasma darah dan sel darah. Sel darah terdiri dari tiga jenis yaitu eritrosit, leukosit dan trombosit. Volume
BAB II TINJAUAN PUSTAKA A. Darah Darah adalah jaringan cair yang terdiri atas dua bagian yaitu plasma darah dan sel darah. Sel darah terdiri dari tiga jenis yaitu eritrosit, leukosit dan trombosit. Volume
HASIL DAN PEMBAHASAN
 16 HASIL DAN PEMBAHASAN Jumlah Eritrosit (Sel Darah Merah) Profil parameter eritrosit yang meliputi jumlah eritrosit, konsentrasi hemoglobin, dan nilai hematokrit kucing kampung (Felis domestica) ditampilkan
16 HASIL DAN PEMBAHASAN Jumlah Eritrosit (Sel Darah Merah) Profil parameter eritrosit yang meliputi jumlah eritrosit, konsentrasi hemoglobin, dan nilai hematokrit kucing kampung (Felis domestica) ditampilkan
MATERI DAN METODE Lokasi dan Waktu Materi Ternak Peralatan Prosedur
 MATERI DAN METODE Lokasi dan Waktu Penelitian ini dilaksanakan di Peternakan Domba Indocement Citeureup, Bogor selama 10 minggu. Penelitian dilakukan pada awal bulan Agustus sampai pertengahan bulan Oktober
MATERI DAN METODE Lokasi dan Waktu Penelitian ini dilaksanakan di Peternakan Domba Indocement Citeureup, Bogor selama 10 minggu. Penelitian dilakukan pada awal bulan Agustus sampai pertengahan bulan Oktober
Darah 8 % bb Komposisi darah : cairan plasma ± 60 % Padatan 40-45% sel darah merah (eritrosit), sel darah putih, trombosit
 Darah 8 % bb Komposisi darah : cairan plasma ± 60 % Padatan 40-45% sel darah merah (eritrosit), sel darah putih, trombosit Plasma (40%-50%) Lekosit Eritrosit sebelum sesudah sentrifusi Eritrosit Fungsi
Darah 8 % bb Komposisi darah : cairan plasma ± 60 % Padatan 40-45% sel darah merah (eritrosit), sel darah putih, trombosit Plasma (40%-50%) Lekosit Eritrosit sebelum sesudah sentrifusi Eritrosit Fungsi
III. MATERI DAN METODE PENELITIAN. Penelitian ini dilaksanakan pada bulan September sampai Oktober 2011, di
 III. MATERI DAN METODE PENELITIAN A. Waktu dan Tempat Penelitian ini dilaksanakan pada bulan September sampai Oktober 2011, di Laboratorium Budidaya Perairan Fakultas Pertanian Universitas Lampung. B.
III. MATERI DAN METODE PENELITIAN A. Waktu dan Tempat Penelitian ini dilaksanakan pada bulan September sampai Oktober 2011, di Laboratorium Budidaya Perairan Fakultas Pertanian Universitas Lampung. B.
